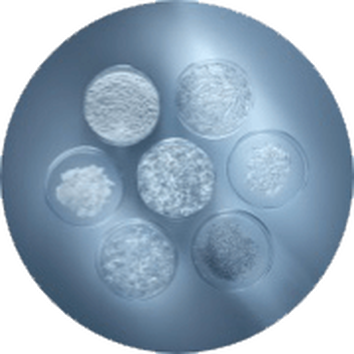

CLARIFIQUE WATERY EMULSION
This skin brightening emulsion's formula is enriched with wild French beech bud extract, a Vitam ... Read full description
PRODUCT BENEFITS
This skin brightening emulsion's formula is enriched with wild French beech bud extract, a Vitamin C derivative & Niacinamide. This brightening emulsion visibly improves skin radiance and a more even-looking skin tone.
Immediately, skin is hydrated up to 24h, feels comfortable and looks mattified.
Skin feels soothed and rebalanced: pores appear visibly tighter and skin texture is refined while being more comfortable.